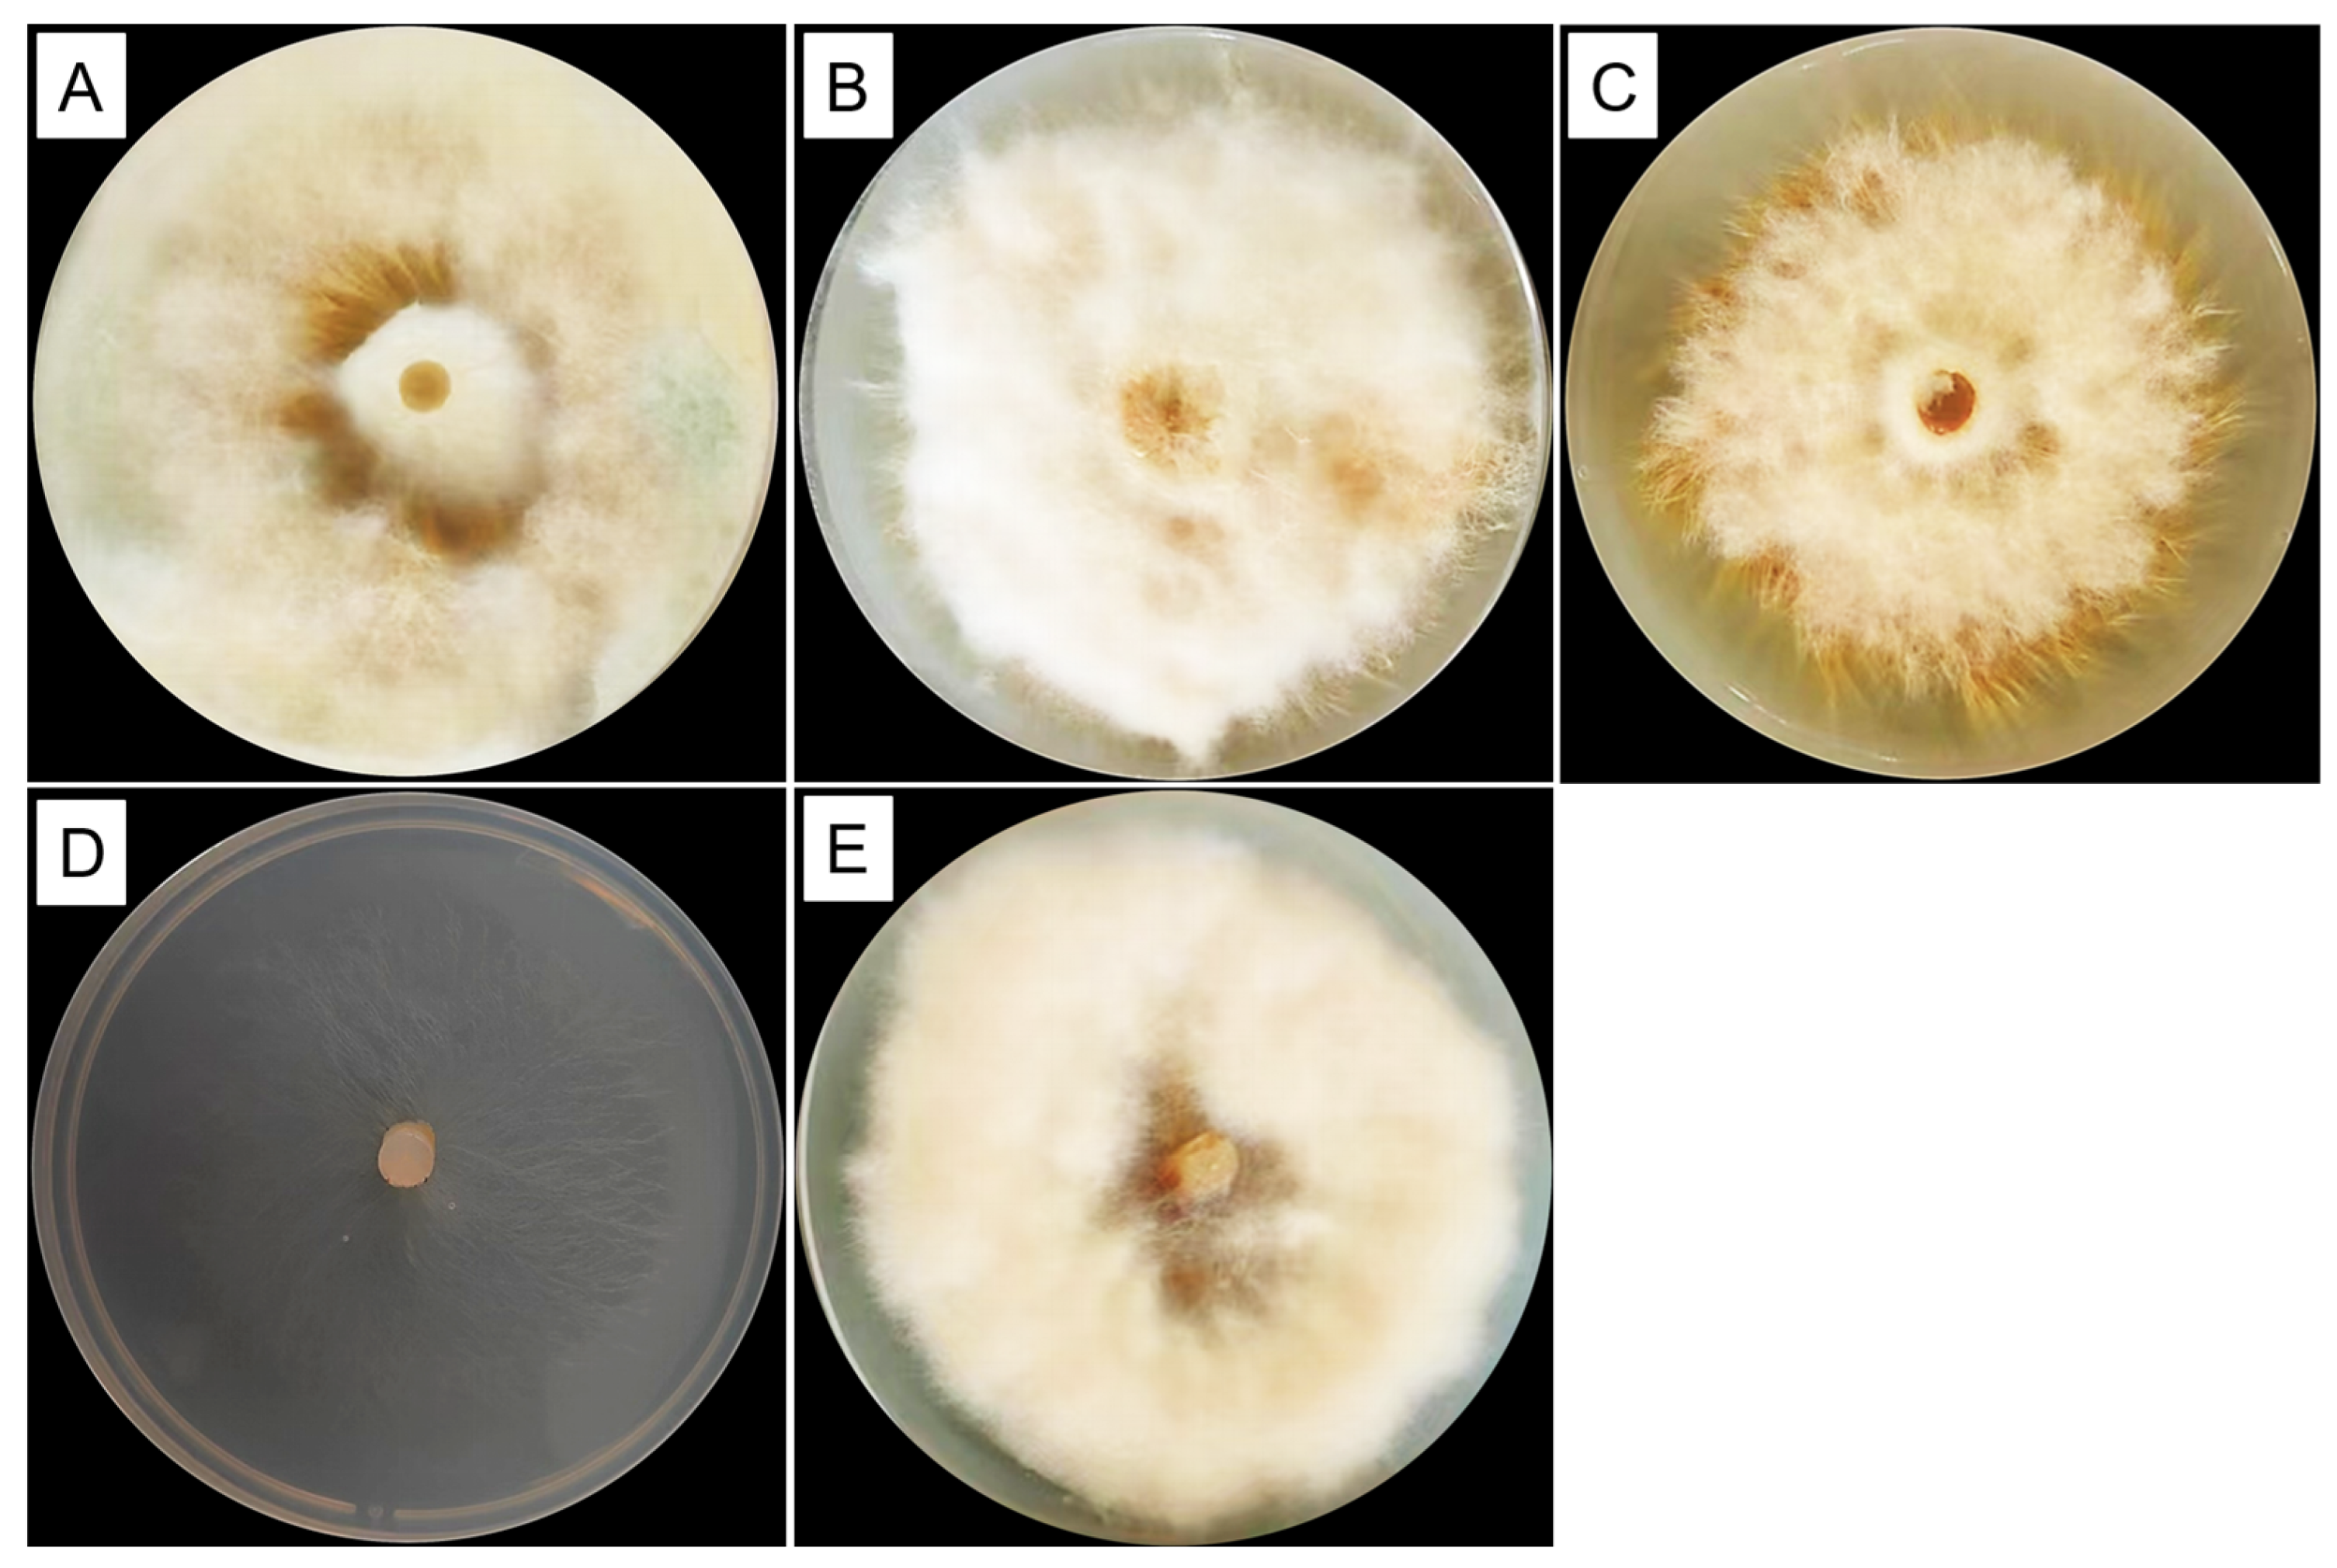
Forests 15 00578 g002
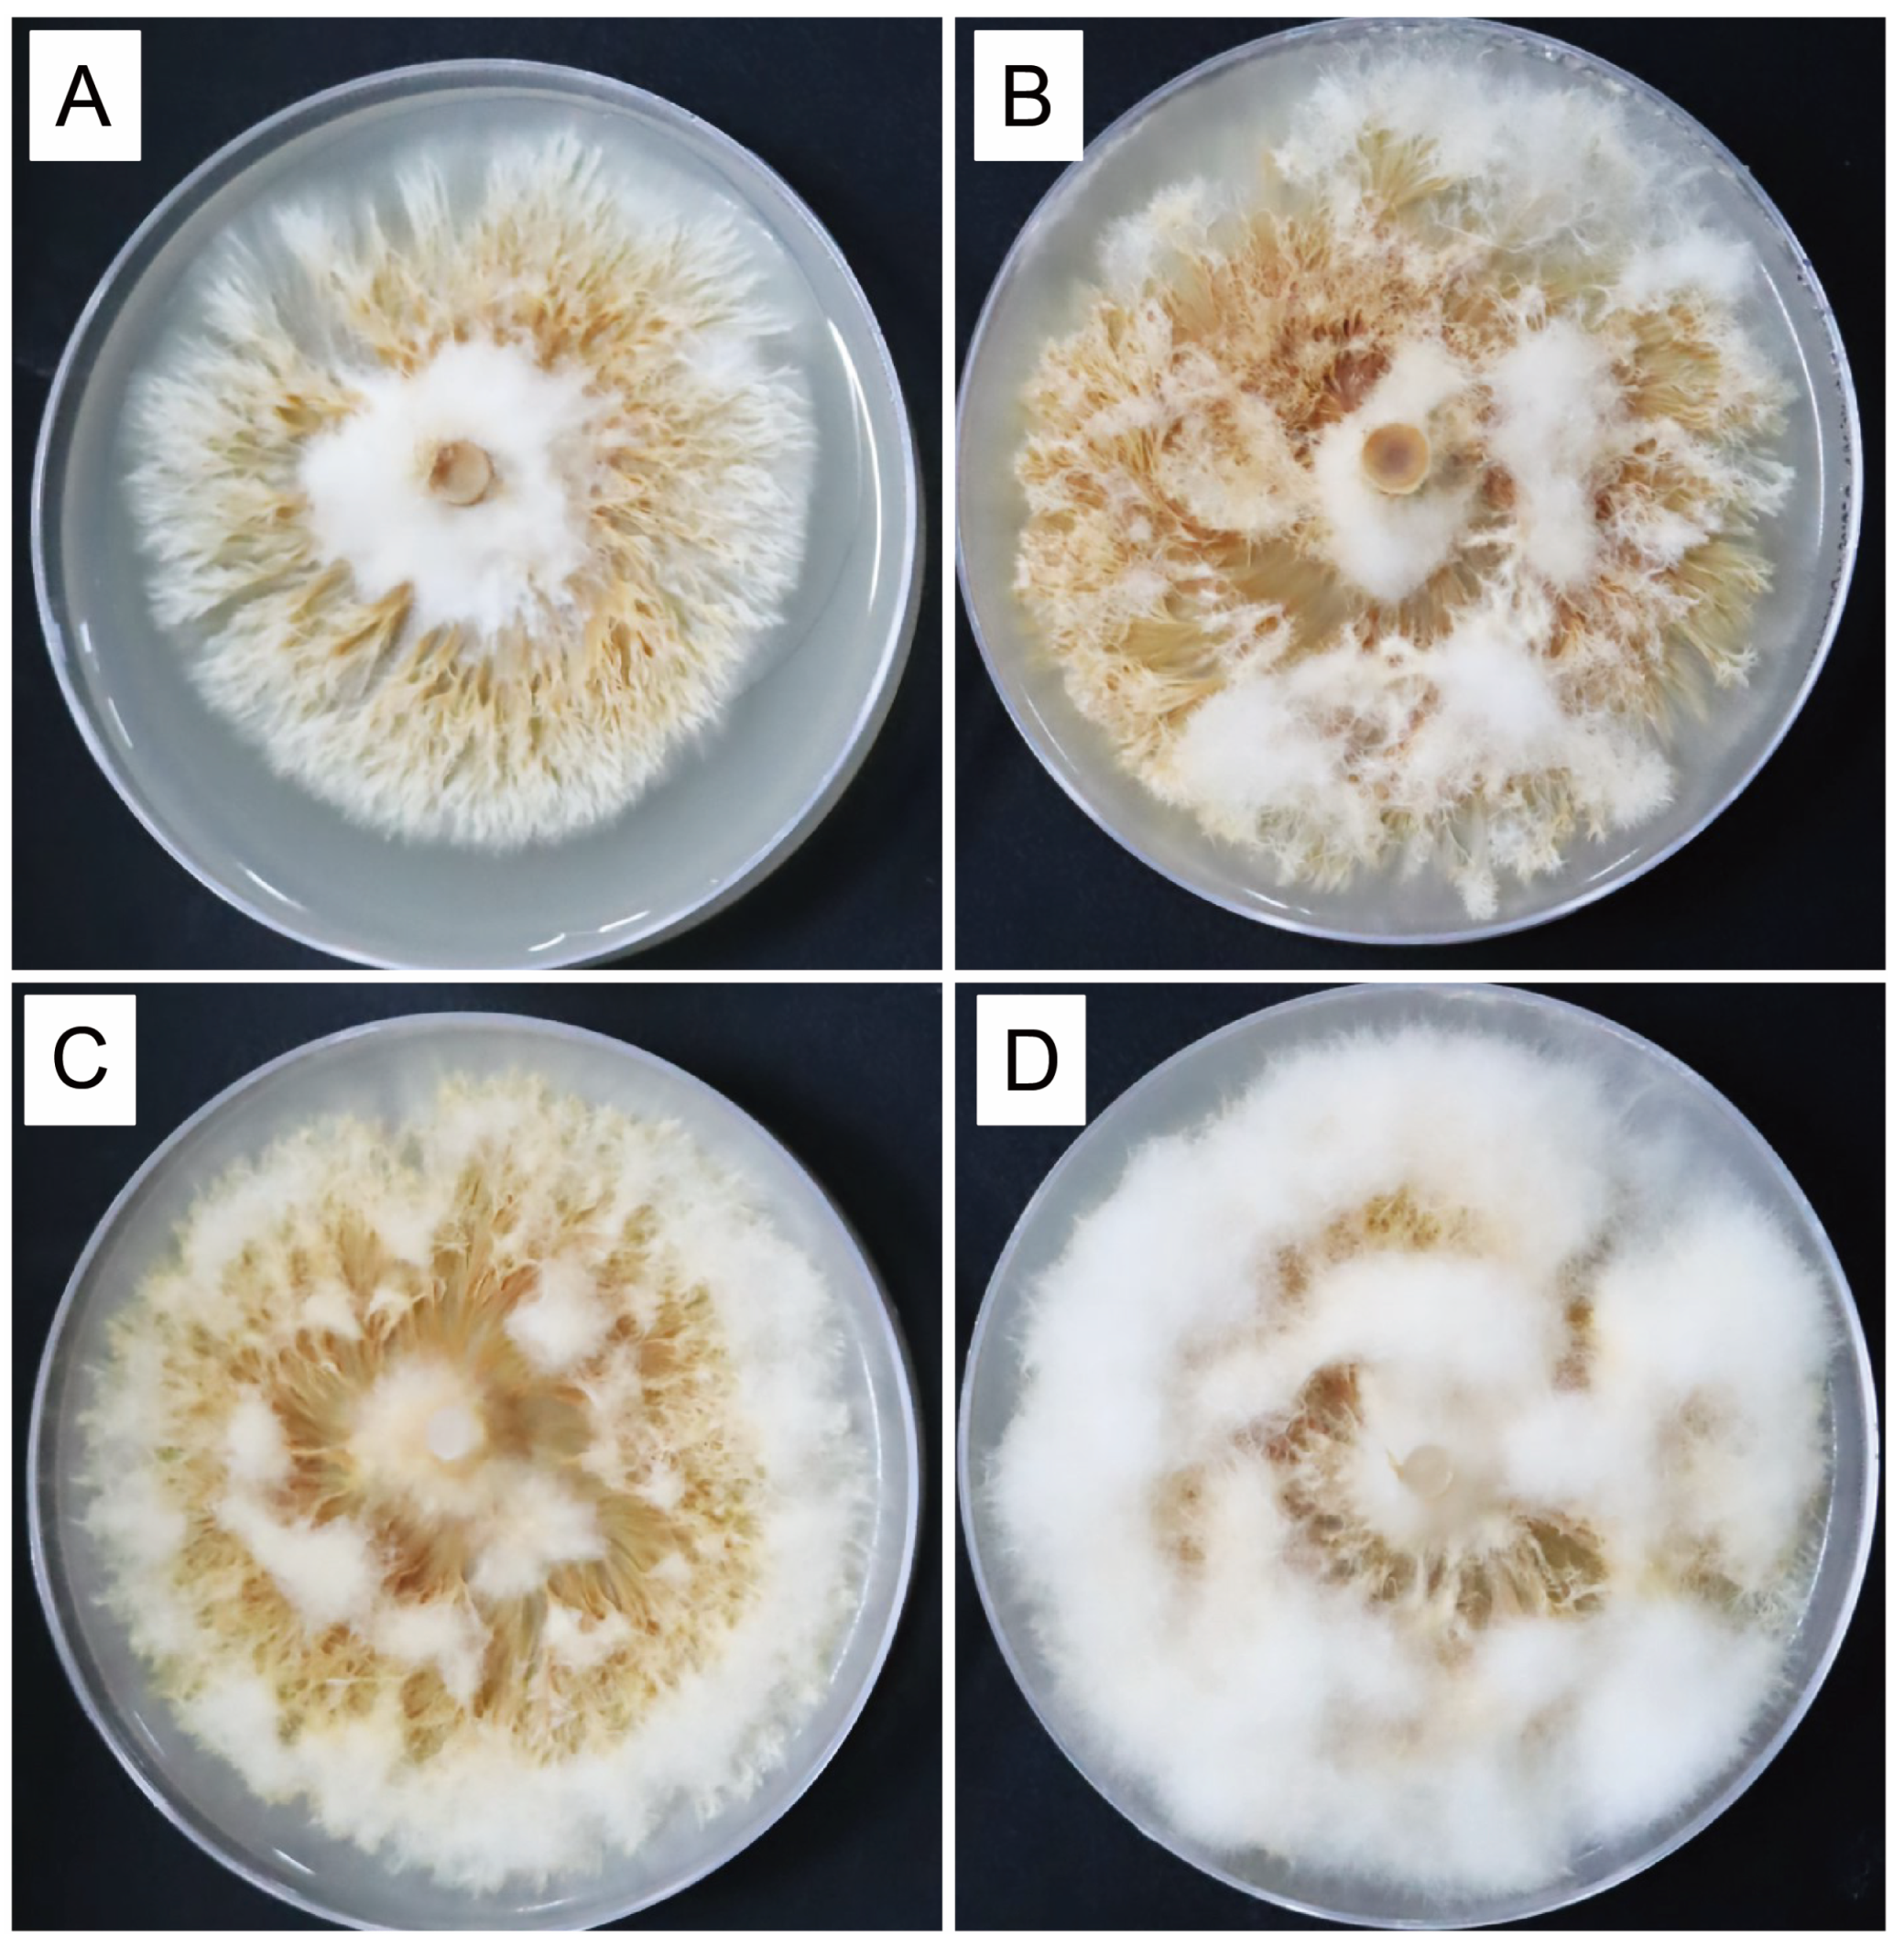
Forests 15 00578 g004

Establishment of Pinus massoniana–Lactarius hatsudake Symbiosis
Abstract
1. Introduction
2. Materials and Methods
2.1. Isolation of Lactarius Hatsudake Strain
2.2. Comparison Medium Composition and Acidity on the Growth of L. hatsudake GX01
2.3. Seed Disinfection Treatment
2.4. Mycorrhizal Synthesis
2.5. Morphological Observations of Ectomycorrhizae
2.6. Molecular Analysis of the Ectomycorrhizae
2.7. Effect of L. hatsudake on the Lateral Roots of P. massoniana Seedlings
2.8. Data Analysis
3. Results
3.1. Comparison of Medium Composition on the Growth of L. hatsudake GX01
3.2. Effects of Acidity on the Growth of L. hatsudake GX01
3.3. Seed Disinfection Treatment
3.4. Mycorrhizal Synthesis between P. massoniana and L. hatsudake GX01
3.5. Effect of L. hatsudake on the Lateral Roots of P. massoniana Seedlings
3.6. Comparison the Anatomical Cross-Sections of Ectomycorrhizal Root
4. Discussion
5. Conclusions
Author Contributions
Funding
Data Availability Statement
Conflicts of Interest
References
- Tedersoo, L.; Bahram, M. Mycorrhizal types differ in ecophysiology and alter plant nutrition and soil processes. Biol. Rev. 2019, 94, 1857–1880. [Google Scholar] [CrossRef] [PubMed]
- Rinaldi, A.C.; Comandini, O.; Kuyper, T.W. Ectomycorrhizal fungal diversity: Seperating the wheat from the chaff. Fungal Divers. 2008, 33, 1–45. [Google Scholar]
- Brundrett, M.C. Mycorrhizal associations and other means of nutrition of vascular plants: Understanding the global diversity of host plants by resolving conflicting information and developing reliable means of diagnosis. Plant Soil 2009, 320, 37–77. [Google Scholar] [CrossRef]
- Brundrett, M.C.; Tedersoo, L. Evolutionary history of mycorrhizal symbioses and global host plant diversity. New Phytol. 2018, 220, 1108–1115. [Google Scholar] [CrossRef] [PubMed]
- Martin, F.; Kohler, A.; Murat, C.; Veneault-Fourrey, C.; Hibbett, D.S. Unearthing the roots of ectomycorrhizal symbioses. Nat. Rev. Microbiol. 2016, 14, 760–773. [Google Scholar] [CrossRef] [PubMed]
- Van Tichelen, K.K.; Colpaert, J.V.; Vangronsveld, J. Ectomycorrhizal protection of Pinus sylvestris against copper toxicity. New Phytol. 2002, 150, 203–213. [Google Scholar] [CrossRef]
- Luo, Z.B.; Wu, C.; Zhang, C.; Li, H.; Lipka, U.; Polle, A. The role of ectomycorrhizas in heavy metal stress tolerance of host plants. Environ. Exp. Bot. 2014, 108, 47–62. [Google Scholar] [CrossRef]
- Bonet, J.A.; de-Miguel, S.; Martínez de Aragón, J.; Pukkala, T.; Palahí, M. Immediate effect of thinning on the yield of Lactarius group deliciosus in Pinus pinaster forests in Northeastern Spain. For. Ecol. Manag. 2012, 265, 211–217. [Google Scholar] [CrossRef]
- De Román, M.; Boa, E. The marketing of Lactarius deliciosus in northern Spain. Econ. Bot. 2006, 60, 284–290. [Google Scholar] [CrossRef]
- Sun, X.; Feng, W.; Li, M.; Shi, J.; Ding, G. Phenology and cultivation of Suillus bovinus, an edible mycorrhizal fungus, in a Pinus massoniana plantation. Can. J. For. Res. 2019, 49, 960–968. [Google Scholar] [CrossRef]
- Guerin-Laguette, A. Successes and challenges in the sustainable cultivation of edible mycorrhizal fungi—Furthering the dream. Mycoscience 2021, 62, 10–28. [Google Scholar] [CrossRef]
- Zhao, Y.; Chai, H.; Chen, W. Discussion on the current development status and sustainable development technologies of China’s wild edible fungi industry. Edible Med. Mushrooms 2021, 29, 372–379. (In Chinese) [Google Scholar]
- Zhao, C.; Sun, D.; Hua, R.; Dong, J.; Liu, Y.; Zhou, X.; Tai, L. Study on development status and sustainable development countermeasures of Tricholoma matsutake industry. Edible Fungi China 2023, 42, 103–109. [Google Scholar] [CrossRef]
- Palahí, M.; Pukkala, T.; Bonet, J.A.; Colinas, C.; Fischer, C.R.; Martínez de Arago’n, J.R. Effect of the inclusion of mushroom values on the optimal management of even-aged pine stands of Catalonia. For. Sci. 2009, 55, 503–511. [Google Scholar]
- Martínez de Aragón, J.; Riera, P.; Giergiczny, M.; Colinas, C. Value of wild mushroom picking as an environmental service. For. Policy Econ. 2011, 13, 419–424. [Google Scholar] [CrossRef]
- Lee, H.; Wissitrassameewong, K.; Park, M.S.; Verbeken, A.; Eimes, J.; Lim, Y.W. Taxonomic revision of the genus Lactarius (Russulales, Basidiomycota) in Korea. Fungal Divers. 2019, 95, 275–335. [Google Scholar] [CrossRef]
- Wang, R.; Guerin-Laguette, A.; Huang, L.L.; Wang, X.H.; Butler, R.; Wang, Y.; Yu, F.Q. Mycorrhizal syntheses between Lactarius spp. section Deliciosi and Pinus spp. and the effects of grazing insects in Yunnan, China. Can. J. For. Res. 2019, 49, 616–627. [Google Scholar] [CrossRef]
- Yang, Q.; Zhang, X.; Qin, H.; Luo, F.; Ren, J. Phenolic acid profiling of Lactarius hatsudake extracts, anti-cancer function and its molecular mechanisms. Foods 2022, 11, 1839. [Google Scholar] [CrossRef] [PubMed]
- Wang, L.; Li, Z.; Zhu, M.; Meng, L.; Wang, H.; Ng, T.B. An acidic feruloyl esterase from the mushroom Lactarius hatsudake: A potential animal feed supplement. Int. J. Biol. Macromol. 2016, 93, 290–295. [Google Scholar] [CrossRef] [PubMed]
- Miyazawa, M.; Kawauchi, Y.; Matsuda, N. Character impact odorants from wild mushroom (Lactarius hatsudake) used in Japanese traditional food. Flavour Fragr. J. 2010, 25, 197–201. [Google Scholar] [CrossRef]
- Tomao, A.; Bonet, J.A.; Martínez de Aragón, J.; de-Miguel, S. Is silviculture able to enhance wild forest mushroom resources? Current knowledge and future perspectives. For. Ecol. Manag. 2017, 402, 102–114. [Google Scholar] [CrossRef]
- Wang, Y.; Hall, I.R.; Dixon, C.; Hance-Halloy, M.; Strong, G.; Brass, P. The cultivation of Lactarius deliciosus (saffron milk cap) and Rhizopogon rubescens (shoro) in New Zealand. In Proceedings of the Second International Conference on Edible Mycorrhizal Mushrooms, Christchurch, New Zealand, 3–6 July 2021; pp. 511–523. [Google Scholar]
- Guerin-Laguette, A.; Cummings, N.; Butler, R.C.; Willows, A.; Hesom-Williams, N.; Li, S.H.; Wang, Y. Lactarius deliciosus and Pinus radiata in New Zealand: Towards the development of innovative gourmet mushroom orchards. Mycorrhiza 2014, 24, 511–523. [Google Scholar] [CrossRef]
- Parladé, J.; Pera, J.; Luque, J. Evaluation of mycelial inocula of edible Lactarius species for the production of Pinus pinaster and P. sylvestris mycorrhizal seedlings under greenhouse conditions. Mycorrhiza 2004, 14, 171–176. [Google Scholar] [CrossRef]
- Yamada, A.; Ogura, T.; Ohmasa, M. Cultivation of mushrooms of edible ectomycorrhizal fungi associated with Pinus densiflora by in vitro mycorrhizal synthesis I. Primordium and basidiocarp formation in open-pot culture. Mycorrhiza 2001, 11, 59–66. [Google Scholar] [CrossRef]
- He, Y.; Ma, J.; Chen, G. Potential geographical distribution and its multi-factor analysis of Pinus massoniana in China based on the maxent model. Ecol. Indic. 2023, 154, 110790. [Google Scholar] [CrossRef]
- Meng, J.; Lu, Y.; Zeng, J. Transformation of a degraded Pinus massoniana plantation into a mixed-species irregular forest: Impacts on stand structure and growth in southern China. Forests 2014, 5, 3199–3221. [Google Scholar] [CrossRef]
- Xu, Q.; Wu, G.; Zeng, R.; Wei, S.; Zhang, X.; Zhang, W.; Chen, J. Developing stand form-height tables of Pinus massoniana plantations in Guangxi. Guangxi For. Sci. 2023, 52, 575–580. (In Chinese) [Google Scholar]
- Yang, Z.; Xia, H.; Tan, J.; Feng, Y.; Huang, Y. Selection of superior families of Pinus massoniana in southern China for large-diameter construction timber. J. For. Res. 2018, 31, 475–484. [Google Scholar] [CrossRef]
- Savoie, J.-M.; Largeteau, M.L. Production of edible mushrooms in forests: Trends in development of a mycosilviculture. Appl. Microbiol. Biotechnol. 2010, 89, 971–979. [Google Scholar] [CrossRef]
- Xue, Z.; Ying, G.; Lv, M.; Li, L.; Gao, F. Studies on mycorrhizal formation of Pinus massoniana inoculated Lactarius hatsudake. Edible Fungi China 2014, 33, 18–19. (In Chinese) [Google Scholar]
- Tan, Z.; Eric, D.; Airong, S.; Fu, S. Successful cultivation of Lactarius hatsutake—An evaluation with molecular methods. Acta Edulis Fungi 2008, 15, 85–88. (In Chinese) [Google Scholar]
- Marx, D.H. The Influence of ectotrophic mycorrhizal fungi on the resistance of pine roots to pathogenic infections. I. Antagonism of mycorrhizal fungi to root pathogenic fungi and soil bacteria. Phytopathology 1969, 59, 153–163. [Google Scholar]
- Wang, R.; Alexis, G.-L.; Yu, F. Optimum media for hyphal growth and mycorrhizal synthesis of two Lactarius species. Mycosystema 2020, 39, 1346–1355. (In Chinese) [Google Scholar]
- Feng, W.; Sun, X.; Ding, G. Morphological and transcriptional characteristics of the symbiotic interaction between Pinus massoniana and Suillus bovinus. J. Fungi 2022, 8, 1162. [Google Scholar] [CrossRef]
- Tamura, K.; Peterson, D.; Peterson, N.; Stecher, G.; Nei, M.; Kumar, S. MEGA5: Molecular evolutionary genetics analysis using maximum likelihood, evolutionary distance, and maximum parsimony methods. Mol. Biol. Evol. 2011, 28, 2731–2739. [Google Scholar] [CrossRef] [PubMed]
- Navarro García, A.; del Pilar Bañón Árias, S.; Morte, A.; Sánchez-Blanco, M.J. Effects of nursery preconditioning through mycorrhizal inoculation and drought in Arbutus unedo L. plants. Mycorrhiza 2010, 21, 53–64. [Google Scholar] [CrossRef] [PubMed]
- Gomes, F.; Suárez, D.; Santos, R.; Silva, M.; Gaspar, D.; Machado, H. Mycorrhizal synthesis between Lactarius deliciosus and Arbutus unedo L. Mycorrhiza 2015, 26, 177–188. [Google Scholar] [CrossRef]
- Li, M.; Wang, H.; Zhao, X.; Feng, W.; Ding, G.; Quan, W. Effect of ectomycorrhizal fungi on the drought resistance of Pinus massoniana seedlings. J. Fungi 2023, 9, 471. [Google Scholar] [CrossRef]
- Kumar, J.; Atri, N.S. Studies on ectomycorrhiza: An appraisal. Bot. Rev. 2017, 84, 108–155. [Google Scholar] [CrossRef]
- Dickie, I.A. Host preference, niches and fungal diversity. New Phytol. 2007, 174, 230–233. [Google Scholar] [CrossRef]
- Pan, X.; Zhang, J.; Xue, Z.; Liang, J.; Chen, Y.; Liu, Y. Synergistic effect of phytohormone-producing ectomycorrhizal fungus Suillus luteus and fertilizer GGR6 on Pinus massoniana growth. J. Plant Interact. 2022, 17, 643–655. [Google Scholar] [CrossRef]
- Montoya, L.; Bandala, V.M.; Garay-Serrano, E. The ectomycorrhizas of Lactarius cuspidoaurantiacus and Lactarius herrerae associated with Alnus acuminata in Central Mexico. Mycorrhiza 2015, 25, 457–467. [Google Scholar] [CrossRef] [PubMed]
- Alvarez, M.; Huygens, D.; Fernandez, C.; Gacitua, Y.; Olivares, E.; Saavedra, I.; Alberdi, M.; Valenzuela, E. Effect of ectomycorrhizal colonization and drought on reactive oxygen species metabolism of Nothofagus dombeyi roots. Tree Physiol. 2009, 29, 1047–1057. [Google Scholar] [CrossRef]
- Bullaín Galardis, M.M.; López Sánchez, R.C.; Fall, F.; Eichler-Löbermann, B.; Pruneau, L.; Bâ, A.M. Growth and physiological responses of ectomycorrhizal Coccoloba uvifera (L.) L. seedlings to salt stress. J. Arid. Environ. 2022, 196, 104650. [Google Scholar] [CrossRef]
- Li, K. Response of Mycorrhizal Pinus massoniana Seedlings to Aluminum Stress. Master’s Thesis, Guizhou University, Guiyang, China, 2019. [Google Scholar]
- Felten, J.; Kohler, A.; Morin, E.; Bhalerao, R.P.; Palme, K.; Martin, F.; Ditengou, F.A.; Legué, V.r. The ectomycorrhizal fungus Laccaria bicolor stimulates lateral root formation in Poplar and Arabidopsis through auxin transport and signaling. Plant Physiol. 2009, 151, 1991–2005. [Google Scholar] [CrossRef]
- Ditengou, F.A.; Müller, A.; Rosenkranz, M.; Felten, J.; Lasok, H.; van Doorn, M.M.; Legué, V.; Palme, K.; Schnitzler, J.-P.; Polle, A. Volatile signalling by sesquiterpenes from ectomycorrhizal fungi reprogrammes root architecture. Nat. Commun. 2015, 6, 6279. [Google Scholar] [CrossRef] [PubMed]
- Horan, D.P.; Chilvers, G.A.; Lapeyrie, F.F. Time sequence of the infection process eucalypt ectomycorrhizas. New Phytol. 2006, 109, 451–458. [Google Scholar] [CrossRef]

| Compound | Formula 1 (PDA) | Formula 2 | Formula 3 | Formula 4 (MMN) | Formula 5 |
|---|---|---|---|---|---|
| Potato extract (g) | 200 | 200 | 200 | - | - |
| Glucose (g) | 20 | 25 | 10 | 10 | 20 |
| Yeast extract (g) | - | 3 | 2 | - | 0.2 |
| KH2PO4 (g) | - | 3 | 1 | 0.5 | 0.34 |
| Peptone (g) | - | - | 4 | - | 2 |
| MgSO4 (g) | - | - | 1 | 0.15 | 0.15 |
| NaCl (g) | - | - | - | 0.025 | 0.025 |
| CaCl2 (g) | - | - | - | 0.05 | 0.05 |
| VB1 (mg) | - | - | - | 0.1 | 0.1 |
| Malt extract (g) | - | - | - | 3 | - |
| (NH4)2HPO4 (g) | - | - | - | 0.25 | - |
| FeCl3 | - | - | - | 0.012 | - |
| NH4Cl (g) | - | - | - | - | 0.56 |
| MES (g) | - | - | - | - | 1.95 |
| Inositol (g) | - | - | - | - | 0.05 |
| Morizet (mL) | - | - | - | - | 0.2 |
| 1% ferric citrate (mL) | - | - | - | - | 3 |
| Agar (g) | 20 | 20 | 20 | 20 | 20 |
| Growth Indicator | Formula 1 | Formula 2 | Formula 3 | Formula 4 | Formula 5 |
|---|---|---|---|---|---|
| Diameter (cm) | 8.500 ± 0.000 d | 5.860 ± 0.110 b | 5.060 ± 0.170 a | 4.960 ± 0.210 a | 6.520 ± 0.360 c |
| Growth rate (cm/day) | 0.258 ± 0.000 d | 0.178 ± 0.003 b | 0.153 ± 0.005 a | 0.150 ± 0.006 a | 0.198 ± 0.011 c |
| Growth Acidity | pH 4.0 | pH 5.0 | pH 6.0 | pH 7.0 |
|---|---|---|---|---|
| Diameter (cm) | 4.920 ± 0.400 b | 8.380 ± 0.240 a | 8.250 ± 0.270 a | 8.500 ± 0.000 a |
| Growth rate (cm/day) | 0.137 ± 0.011 b | 0.233 ± 0.007 a | 0.229 ± 0.007 a | 0.236 ± 0.000 a |
| Sterilization Effects | 0.5% KMnO4 | 30% H2O2 | ||||||
|---|---|---|---|---|---|---|---|---|
| 15 min | 20 min | 30 min | 40 min | 4 min | 5 min | 10 min | 15 min | |
| Contamination rate (%) | 79 | 58 | 55 | 33 | 8 | 2 | 3 | 2 |
| Germination rate (%) | 53 | 60 | 58 | 60 | 85 | 67 | 43 | 41 |
| Germ-free seedling rate (%) | 16 | 34 | 29 | 45 | 77 | 65 | 42 | 41 |
| Extraction Site | Mantle Thickness (μm) | Mycelium Average Pore Size (μm) |
|---|---|---|
| a | 9.48 | 3.29 |
| b | 17.23 | 2.50 |
| c | 20.70 | 2.35 |
| d | ND | ND |
Disclaimer/Publisher’s Note: The statements, opinions and data contained in all publications are solely those of the individual author(s) and contributor(s) and not of MDPI and/or the editor(s). MDPI and/or the editor(s) disclaim responsibility for any injury to people or property resulting from any ideas, methods, instructions or products referred to in the content. |
© 2024 by the authors. Licensee MDPI, Basel, Switzerland. This article is an open access article distributed under the terms and conditions of the Creative Commons Attribution (CC BY) license (https://creativecommons.org/licenses/by/4.0/).
Share and Cite
Wei, Z.; Liu, L.; Lei, Y.; Xie, S.; Ma, J.; Tan, Y.; Tang, N.; Yang, Z.; Ai, C. Establishment of Pinus massoniana–Lactarius hatsudake Symbiosis. Forests 2024, 15, 578. https://doi.org/10.3390/f15040578
Wei Z, Liu L, Lei Y, Xie S, Ma J, Tan Y, Tang N, Yang Z, Ai C. Establishment of Pinus massoniana–Lactarius hatsudake Symbiosis. Forests. 2024; 15(4):578. https://doi.org/10.3390/f15040578
Chicago/Turabian StyleWei, Zhineng, Lin Liu, Yidan Lei, Sisi Xie, Jiangming Ma, Yibo Tan, Nianwu Tang, Zhangqi Yang, and Chenbing Ai. 2024. "Establishment of Pinus massoniana–Lactarius hatsudake Symbiosis" Forests 15, no. 4: 578. https://doi.org/10.3390/f15040578
APA StyleWei, Z., Liu, L., Lei, Y., Xie, S., Ma, J., Tan, Y., Tang, N., Yang, Z., & Ai, C. (2024). Establishment of Pinus massoniana–Lactarius hatsudake Symbiosis. Forests, 15(4), 578. https://doi.org/10.3390/f15040578

